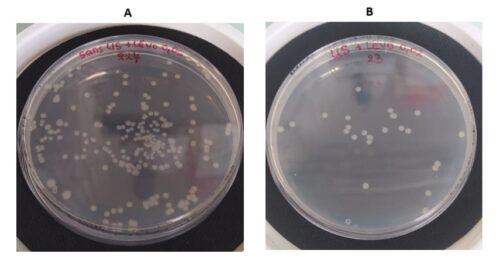

Sommaire
Karim Ghoufiri
Business Developper
Technologie
- Méthode de cryoconservation non toxique (plateforme de congélation directionnelle précédemment décrite) pour des cellules en suspension libre dans une solution aqueuse isotonique, utilisant une nouvelle approche de congélation dirigée qui élimine le besoin de cryoprotecteurs toxiques.
Marché
- Applications suggérées : biobanques médicales, thérapie cellulaire, développement de lignées cellulaires, techniques de procréation médicalement assistée (PMA), recherche universitaire.
- Avantages concurrentiels : non toxique, simplification de la chaîne de valeur de la cryoconservation, coût inférieur aux méthodes traditionnelles, absence d’étape de lavage du cryoprotecteur.
Niveau de développement
- PoC sur globules rouges : mise en évidence d’une activité estérase (viabilité) ; après stockage pendant plus de 100j à -80°C:
- 95 % aux concentrations sous-physiologiques
- 80 % aux concentrations physiologiques.
- PoC sur cellules nuclées (fibroblastes murins et humains)
- Programme de maturation en cours : (i) développement d’un prototype capable de contrôler la congélation dans des poches commerciales, (ii) mise à l’échelle du dispositif de congélation directionnelle, (iii) tests fonctionnels sur des cellules d’intérêt après congélation/décongélation et (iv) stockage et le transport à long terme.
PI
- Demande de brevet déposée le 22 mars 2022
- Numéro de publication : WO2023180635
- Phase nationale/régionale : Australie, Canada, États-Unis, Israël, Japon, Europe
Stratégie de valorisation
- Licensing